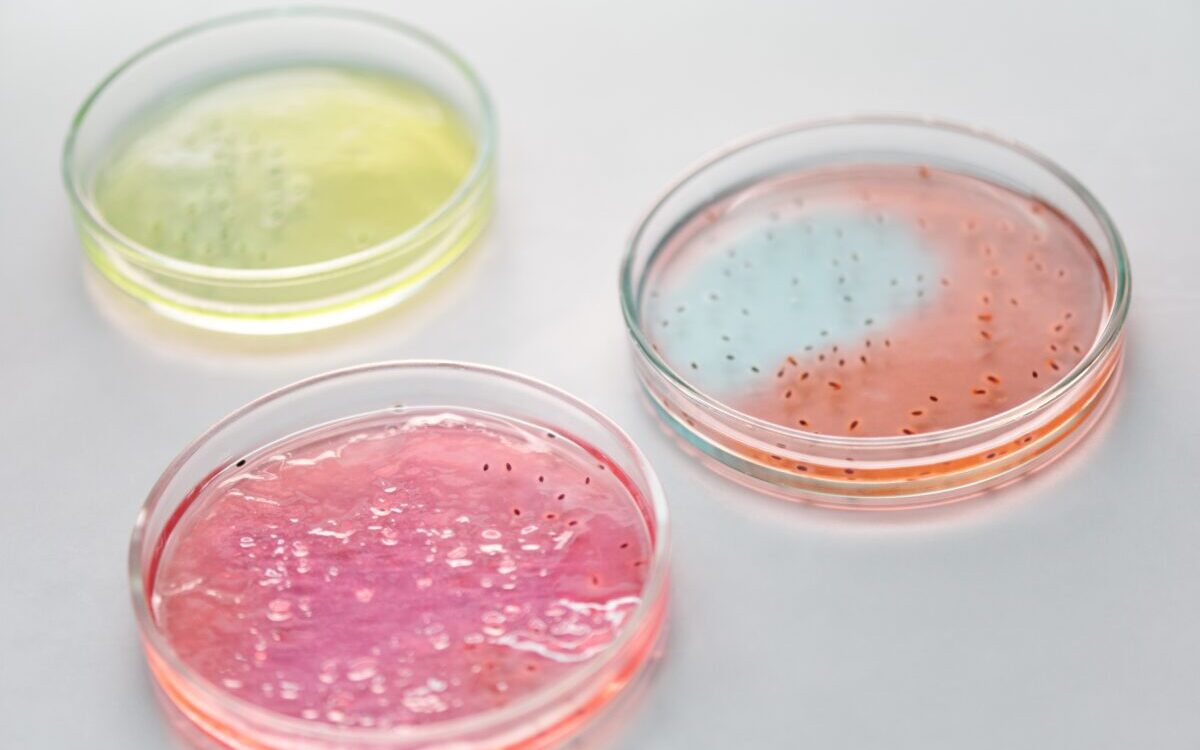
Food Science & Technology Quiz (15/12/2020)

Food Science & Technology Quiz (15/12/2020)
Q1. Tomato Ketchup Is a Good Example Of?
A} Newtonian Fluid
B} Pseudoplastic
C} Non-Newtonian Fluid
D} Both A And C
ANSWER – Both A And C
In Non-Newtonian Fluids, Viscosity Can Change When Under Force To Either More Liquid Or More Solid. Ketchup, ...
0